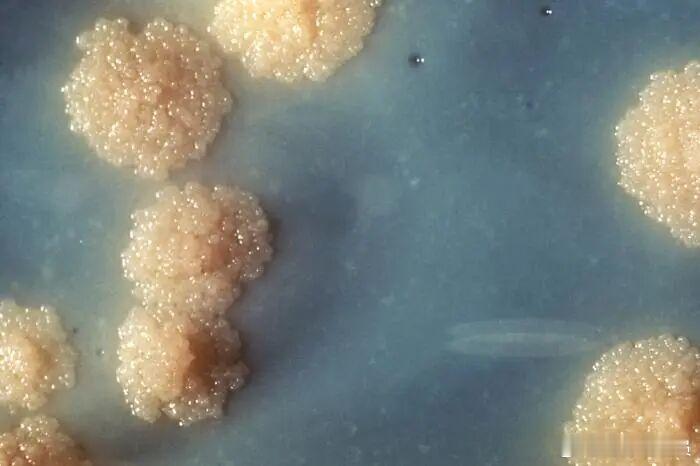

罕见病例:男子阴茎感染结核菌,疑与狩猎屠宰有关!近日,一项发表于《美国微生物学会-病例报告》(ASM Case Reports)的研究披露,一名57岁爱尔兰男性因阴茎红肿、疼痛并伴有发热入院,最终被确诊为罕见的阴茎结核感染。该患者有肾脏移植史,长期服用免疫抑制剂,导致免疫力较低。入院初期,医生按常规细菌感染治疗,但病情持续恶化。进一步问诊发现,患者此前三个月已有发热、盗汗、体重下降等症状,且有长期接触动物尸体的经历——他曾在农场从事鹿、牛屠宰工作,并热衷野外狩猎。CT检查显示,其肺部布满粟粒状结节,符合粟粒性结核的特征。结核分枝杆菌或其近亲牛分枝杆菌可能通过空气传播或直接接触感染。尽管结核菌可侵袭全身,但阴茎感染极为罕见,在泌尿生殖系统结核中占比不足1%。结合患者免疫抑制状态及肺部病情,医生推测其阴茎病变为结核感染所致。检测证实其呼吸道和阴茎组织均存在分枝杆菌。医生为其制定了为期12个月的联合抗生素方案,期间患者阴茎病变一度恶化,形成坏死性溃疡,需手术清创。治疗十个月后,感染基本清除,病情显著改善。感染来源至今未明,患者未接触结核病患者,也未到过常见传播场所。医生推测可能与其狩猎、屠宰经历有关,可能通过吸入或接触感染动物而传播。感染究竟始于肺部还是直接发生在阴茎,仍无法确定。医生们还注意到,2001 年英国的一份病例报告显示,一名男子罹患阴茎结核,其伴侣一年后出现子宫结核,这暗示了性传播的可能性。尽管感染途径成谜,但此类病例对抗结核治疗反应良好。历史记录显示,所有报告的阴茎结核患者均完全康复,此例亦不例外。热门微博 医学新闻 结核病 环球见闻